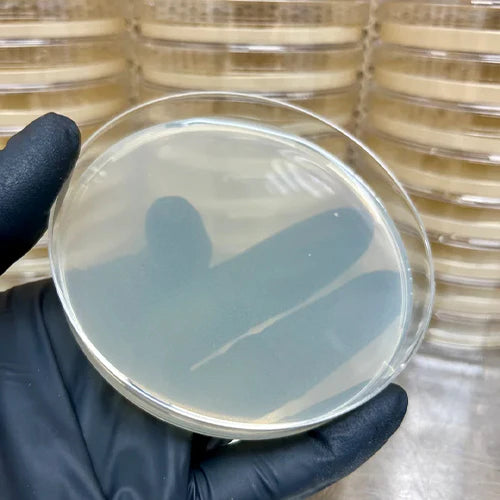
Sterile Agar Plates

Filters
Filters
Magic Spore Labs
Magic Spore Labs stands out as a trusted source for premium mushroom spores, perfect for enthusiasts interested in exploring the fascinating world of mycology. With a focus on quality, Magic Spore Labs provides an extensive range of spores, from popular strains like Golden Teacher to more exotic varieties that offer unique characteristics. Each spore is carefully cultivated and meticulously packaged to ensure optimal freshness and viability, giving you the best possible start for your mushroom cultivation journey. The brand's dedication to excellence means you can count on high-quality products that meet your expectations, whether you're expanding your spore collection or just beginning to explore the possibilities.
What sets Magic Spore Labs apart is their commitment to providing a wide selection that caters to both hobbyists and more experienced cultivators. The user-friendly approach and detailed strain information make it easy to find the perfect match for your needs. From spore syringes to prints, every product is designed to support successful cultivation, with a focus on purity and authenticity. With Magic Spore Labs, you’re not just purchasing spores; you’re investing in a top-tier experience that brings you closer to the intriguing world of mushrooms. Dive into their collection and discover why so many trust Magic Spore Labs for their mycological needs.